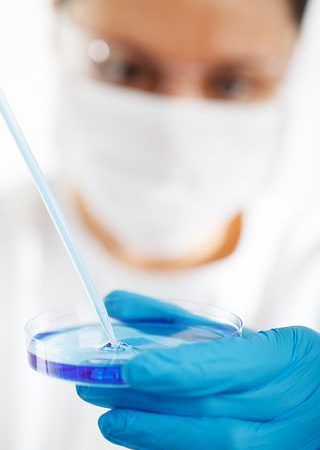
Kiedy tak właściwie udać się na wizytę do laryngologa?

Strefy SPA oferują relaks nie jedynie dla ciała, jakkolwiek także dla ducha. Dokładnie to samo tyczy się poprawiania urody. Przez zabiegi na ciało zdecydowanie poprawia się stan ducha i właśnie to z reguły czyni człowieka znacznie bardziej zrelaksowanym oraz spokojnym….
Rzetelne wykonywanie testu prenatalnego NIFTY PLUS BY GENEPLANET umożliwione jest w placówce Blumedica. To centrum ginekologiczne w Poznaniu cieszy się dużą renomą, o czym poświadcza między innymi umieszczenie w ofercie https://www.blumedica.pl/test-prenatalny-nifty-poznan/, wskazujące, że są w tym miejscu przeprowadzane unowocześnione badania…
Kolebka Smaku to sklep www w którym można zakupić wysokiej jakości oliwy extra virgin. Kompletny zbiór produktów jest tutaj podzielony na pochodzące z Grecji i pochodzące z Hiszpanii oliwy. Ich klasa może być filtrowana lub premium. Ceny za wybrane produkty…
Sporadycznie napotyka się trudniejszą i o wiele bardziej złożoną dziedzinę wiedzy aniżeli medycyna. Od zawsze budziła ona podziw oraz zaciekawienie ludzi. Dbanie o prawidłowe funkcjonowanie ciała człowieka oraz zdolność rozpoznania groźnych chorób powodowały, iż lekarze od początku historii medycyny cieszyli…
Jest to postać z wykształceniem wyższym medycznym. Pragnąc wykonywać ten zawód należy się przygotować na gigantyczny zasób wiedzy specjalistycznej, ale w oryginalnej fazie nauki na medycynę całościową. Studia na tym kierunku to przede wszystkim dużo lat nauki, albowiem nawet po…
Wskazówki dzięki jakim kobiety w ciąży mogą przyszykować się do porodu i poczuć bezpieczniej opublikowane są na portalu parentingowym https://blogbaby.pl/bol-porodowy/. To cenne rady od ginekologów i położnych, jakie głównie mogą przydać się kobietom, które są pierwszy raz w ciąży. Mają…
Zasady prawidłowej higieny jamy ustnej są legendarne właściwie wszystkim, bowiem wpajane są już od najmłodszych lat. Koncerny tworzące pasty do mycia zębów i inne akcesoria do higieny jamy doustnej prześcigają się w tworzeniu kampanii reklamowych nie jedynie swoich artykułów niemniej…
Lekarz, który zajmuje się specjalizacją, którą jest laryngologia, na co dzień w większości wypadków bada, diagnozuje oraz kuruje choroby ucha, nosa, krtani, a także gardła. W większości wypadków ludzi zgłaszają się do lekarza o tej specjalności, kiedy tak właściwie mają…
Włosy to tylko tak zwane nitkowate twory, które znajdują się na powierzchni cery, pochodzenia naskórkowego. Tak przedstawia się włosy z perspektywy definicji naukowej, jednak dla ludzi czynnie asystujących w życiu społecznym i towarzyskim, a w szczególności dla dam, dla jakich…
Wątroba to dość istotny organ w każdym organizmie ludzkim. Bez niej nie byłoby dopuszczalnych wiele procesów, w głównej mierze trawiennych i metabolicznych. Jeżeli pragniemy utrzymać naszą przejrzystą wątrobę w należytej kondycji, z całą pewnością trzeba o nią dbać, bo w…